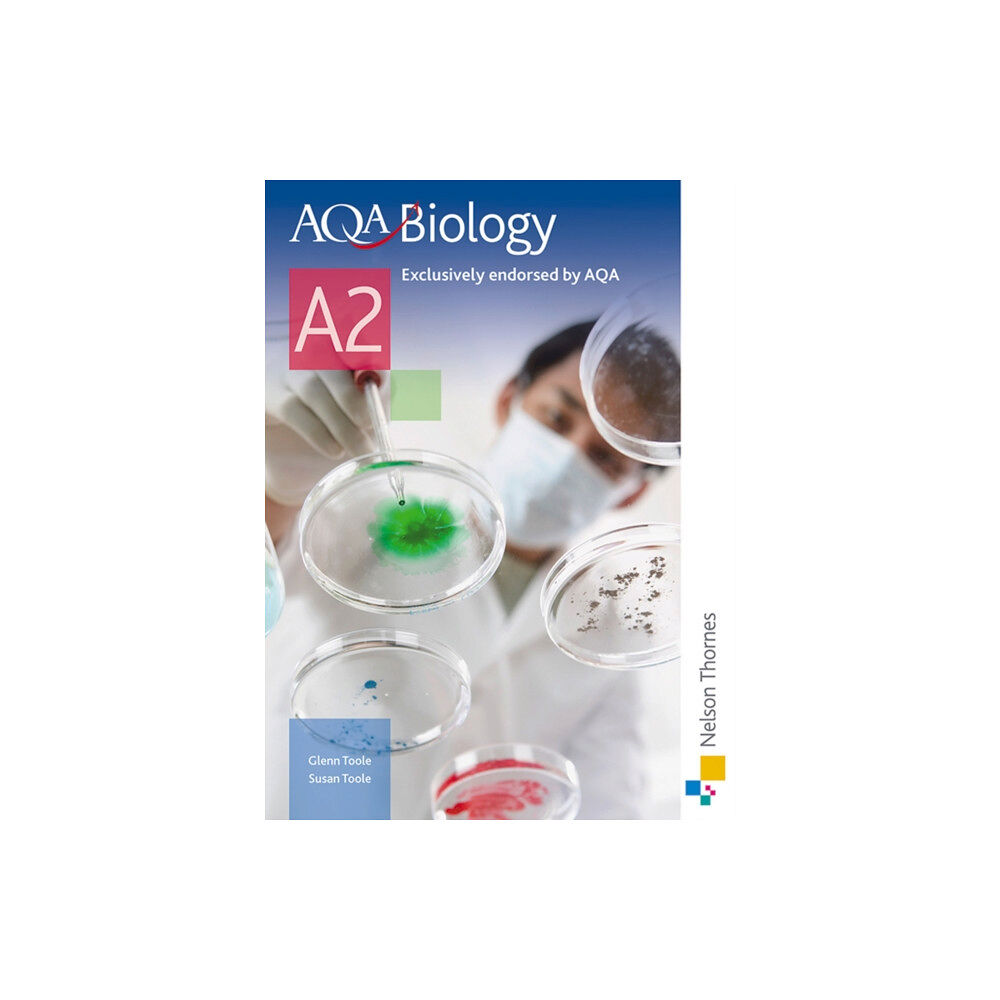
Oxford University Press AQA Biology A2 Student Book (häftad, eng)

AQA Biology A2 Student Book (häftad, eng)
Supports your students and helps them develop the skills required to tackle How Science Works and practical assessment.
269 kr
349 kr
inkl. moms
I lager
Skickas inom 3 - 4 vardagar
EAN: 9780748798131
Specifikation
Böcker
- Format Häftad
- Antal sidor 328
- Språk Engelska
- Förlag Oxford University Press
- Utgivningsdatum 2008-11-21
- ISBN 9780748798131
Tillagd i varukorgen